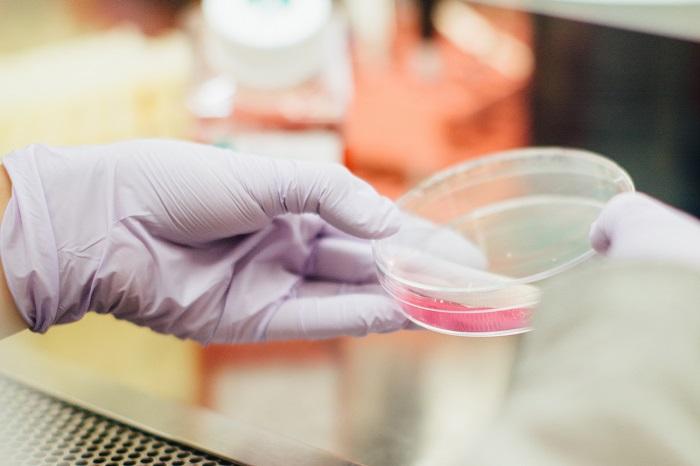

Нижегородский вуз получит финансирование на разработку платформы для создания вакцины от рака
- 7 октября 2024
Средства будут направлены по итогам совместного конкурса Нижегородского НОЦ и ГК «Мадин»
Нижегородский научно-образовательный центр (НОЦ) и ГК «Мадин» подвели итоги конкурса инновационных проектов в области высокотехнологичной персонализированной медицины. НОЦ осуществляет свою деятельность в рамках нацпроекта «Наука и университеты».
Победителем конкурса был признан проект ФГАОУ ВО «Национальный исследовательский Нижегородский государственный университет им. Н.И. Лобачевского». Команда ученых вуза займутся разработкой мРНК-платформы для противораковых вакцин в составе новых наноконтейнеров. Такая платформа может быть использована для создания персонализированных вакцин и препаратов, изменяющих иммуносупрессивную микросреду опухоли. Технология призвана увеличить эффективность лечения онкологических пациентов.
«В числе основных задач Нижегородского НОЦ – помощь в налаживании взаимодействия между научными организациями и бизнесом. Совместные конкурсы относятся к инструментам для ее решения, и сегодня мы подводим итоги одного из таких конкурсов. Авторы проекта-победителя получат финансовую поддержку в размере 20 миллионов рублей. Средства в равных долях предоставит НОЦ и индустриальный партнер», - рассказал заместитель губернатора Нижегородской области Андрей Саносян.
В рамках конкурса на выполнение технических заданий индустриального партнера было представлено три проекта от ведущих университетов региона. Каждая заявка прошла экспертную оценку по таким параметрам, как инновационная составляющая проекта, квалификация и опыт работы коллектива, конкурентоспособность проекта и др.
«Для нашей компании это первый опыт участия в подобном конкурсе. Все заявки, поступившие на конкурс, достойны внимания. Мы рады быть частью процесса, который помогает развивать инновации и двигать рынок инновационной медицины вперед», — подчеркнул директор ООО НПФ «Реабилитационные технологии» (входит в ГК «Мадин») Александр Емельянов.
В этом году Нижегородский НОЦ объявил о проведении совместно с индустриальными партнерами пяти конкурсов инновационных проектов. Они направлены на развитие отраслей железнодорожного сообщения, высокотехнологичной медицины, станкостроения и химии.
«Для Нижегородского НОЦ важно, чтобы процесс создания инноваций включал кооперацию вузов и научных институтов региона с предприятиями реального сектора экономики. Основная цель проведения конкурсов совместно с индустриальными партнерами – решение реальных производственных задач. Такой подход позволяет достичь максимального синергетического эффекта», - рассказал директор Нижегородского НОЦ Александр Тарасенко.
Напомним, НОЦ в Нижегородской области признан одним из лидеров, входящих в тройку научно-образовательных центров по итогам деятельности за 2023 год, среди всех созданных НОЦ в России в рамках национального проекта «Наука и университеты».
Нацпроект реализуется в стране по инициативе президента РФ Владимира Путина с 2018 года. Он включает в себя четыре федеральных проекта: «Развитие интеграционных процессов в сфере науки, высшего образования и индустрии», «Развитие масштабных научных и научно-технологических проектов по приоритетным исследовательским направлениям», «Развитие инфраструктуры для научных исследований и подготовки кадров» и «Развитие человеческого капитала в интересах регионов, отраслей и сектора исследований и разработок».
Ознакомиться с возможностями, которые предоставляет бизнесу и научным организациям Нижегородский НОЦ, можно на сайте организации: https://science52.ru/.
Период с 2022-го по 2031 год Указом Президента РФ Владимира Путина объявлен Десятилетием науки и технологий в России. Основные задачи Десятилетия – привлечение талантливой молодежи в сферу исследований и разработок, вовлечение исследователей и разработчиков в решение важнейших задач развития общества и страны, а также повышение информированности россиян о достижениях и перспективах отечественной науки. Со всей актуальной информацией о проекте и его инициативах можно ознакомиться на сайте: наука.рф.
Социальные сети Нижегородского НОЦ:
- Telegram: https://t.me/noc52_news;
- VK: https://vk.com/noc_nn.
